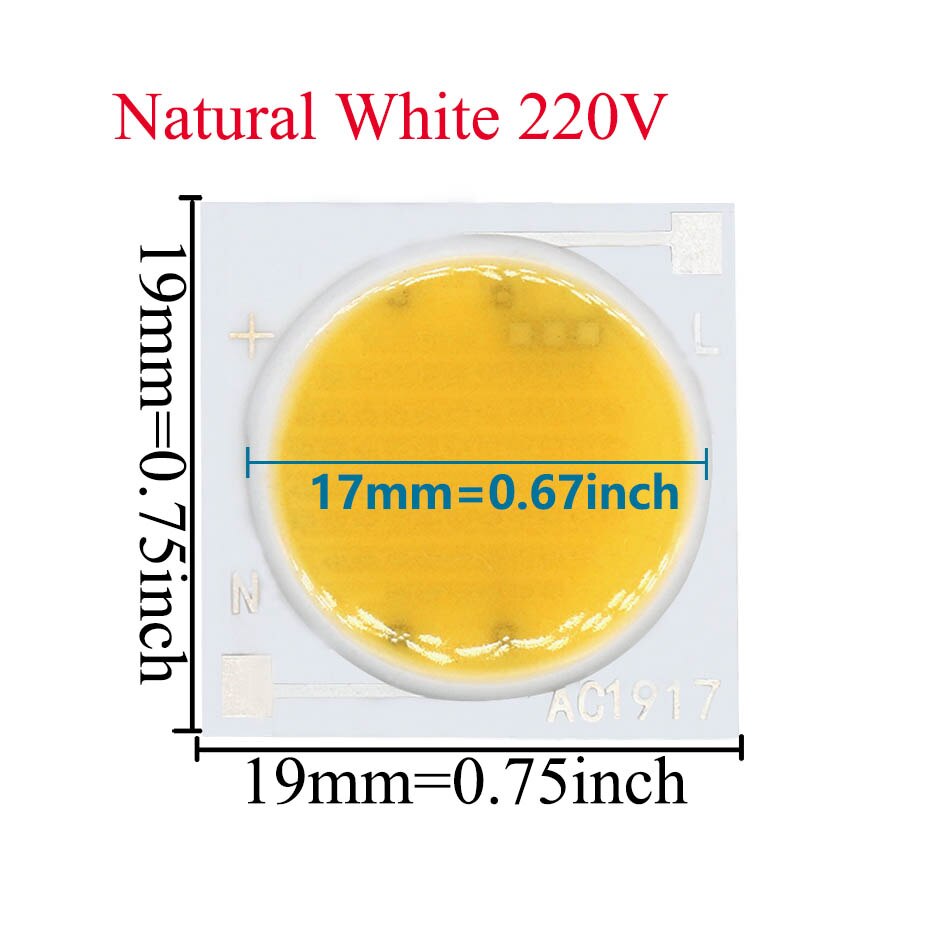
10PCS 220V 50W 20W 30W 15W 12W LED Ceramic chip COB Bulb led Led for flashlight spotlights chip led Bulb diode lamp white: Naturalwhite / 50W 10PCS

- Free shipping
- Free returns*
- Low prices
- 5 million products
10PCS 220V 50W 20W 30W 15W 12W LED Ceramic chip COB Bulb led Led for flashlight spotlights chip led Bulb diode lamp white
Specifications:
- Brand Name: BING&SEN
- Certification: ROHS
- COLOR: Coldwhite/Warmwhite
- Item Type: BALL
- Model Number: 1
- Origin: CN(Origin)
- Power: 12W/15W/20W/30W/50W
- Size: 19x19mm
- Type: Ceramic chip

- Free shipping
- Free returns*
- Low prices
- 5 million products